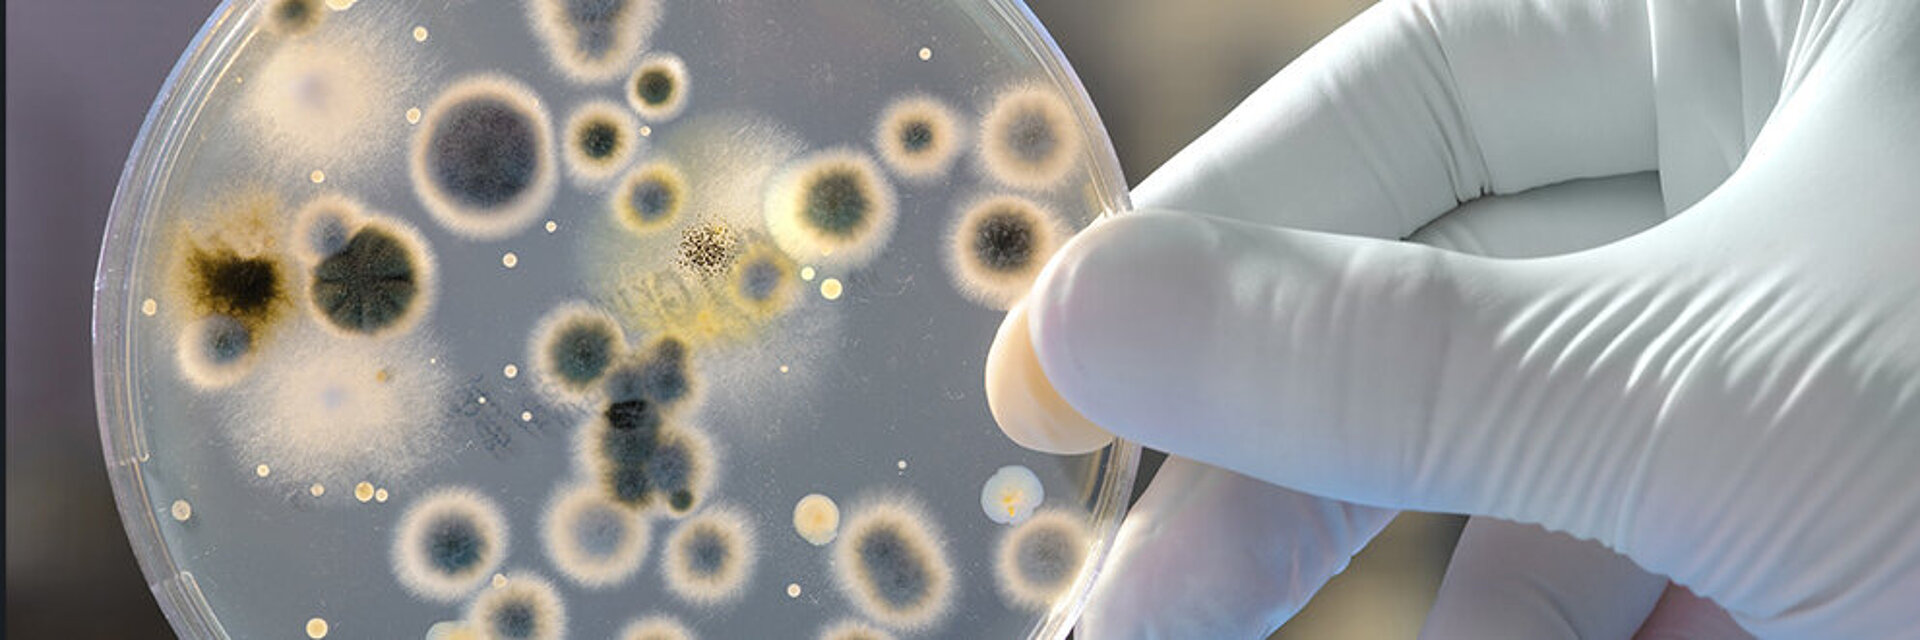

Age-related degenerative joint diseases, such as osteoarthritis of the hip and knee, are a major cause of disability globally and a huge problem for healthcare systems worldwide.1 Total joint arthroplasty is one of the most successful orthopedic procedures that has reduced pain and regained joint function in millions of osteoarthritis patients worldwide.2 Nevertheless, 5-10% of patients undergoing total hip and knee arthroplasty will have to undergo revision surgery with the exchange of the prosthesis at 10 years after the primary procedure.3
Aseptic or septic?
One of the most common reasons for revision of a joint replacement is aseptic loosening, which can be related to inadequate primary stability, mechanical weakening of fixation over time and particle-induced bone resorption.4 Particles may be generated by wear, mechanically assisted corrosion at the taper junction, oxidation reactions and demineralization by pathogens. Metal ions released by biocorrosion products, although playing a subordinate role compared to wear particles, also increase the excretion of inflammatory markers, which can contribute to aseptic loosening. As millions of joint replacements are implanted each year and the patient population is increasingly active, the growth of revision surgeries is significant and represents a burden for the current healthcare system and even more so for the future. As such, it may not be sustainable henceforth, as revisions are associated with 3 to 8 times higher mortality rates, poorer clinical outcomes, and much higher costs than primary operations.3
One of the most serious complications leading to challenging revisions is extensive tissue damage caused by adverse local tissue reactions from metal debris (ARMD) and toxic metal ions.5 Revision for ARMD can often end with a complication associated to major revision procedures, of which the most serious one remains the periprosthetic joint infection (PJI). Whereas PJI is cause of revision for 2-3% of primary procedures, it is also the reason for up to 10% of re-revision procedures.3 It is disabling for patients, impairing quality of life, requires very invasive treatment, and there is a high risk of significant adverse events. The mortality rate of revisions for infection is five times that for aseptic reasons and the risk of sepsis in revisions is seven times higher compared to primary procedures, with consequent increase of morbidity and mortality.
However, the number of infections may be significantly underestimated, as differentiation between aseptic and septic loosening remains difficult due to similar clinical symptoms and radiographic findings, so that a significant number of misdiagnoses are assumed.4,6 Bacteria activate the host immune system and can cause implant loosening. Therefore, bone resorption with moderate pain and radiographic findings observed in aseptic loosening may also be the result of infection, usually caused by low-virulent bacteria. It follows that low-grade PJIs also referred to as subclinical or occult, may be unsuspected and with undetectable symptoms and as a consequence may contribute to prosthetic failure diagnosed as aseptic. Therefore, the diagnostic pitfall is a major current problem, and early detection of infection remains crucial to the successful treatment of PJI. Infection must always be ruled out in every case, as underdiagnosis risks adverse outcomes with inappropriate treatment aimed at aseptic revision when infection is present, often leading to subsequent invasive treatment. Unfortunately, correctly distinguishing infection from aseptic failure is a real problem in clinical practice and, more importantly, depends on the diagnostic threshold used, awareness and acute clinical suspicion.6
No single diagnostic approach has gained acceptance as a reference standard for clinical practice. Clearly, in this scenario, the best strategy may firstly be avoiding all possible modifiable risks in the primary procedure.6
However, the number of infections may be significantly underestimated, as differentiation between aseptic and septic loosening remains difficult due to similar clinical symptoms and radiographic findings, so that a significant number of misdiagnoses are assumed.4,6 Bacteria activate the host immune system and can cause implant loosening. Therefore, bone resorption with moderate pain and radiographic findings observed in aseptic loosening may also be the result of infection, usually caused by low-virulent bacteria. It follows that low-grade PJIs also referred to as subclinical or occult, may be unsuspected and with undetectable symptoms and as a consequence may contribute to prosthetic failure diagnosed as aseptic. Therefore, the diagnostic pitfall is a major current problem, and early detection of infection remains crucial to the successful treatment of PJI. Infection must always be ruled out in every case, as underdiagnosis risks adverse outcomes with inappropriate treatment aimed at aseptic revision when infection is present, often leading to subsequent invasive treatment. Unfortunately, correctly distinguishing infection from aseptic failure is a real problem in clinical practice and, more importantly, depends on the diagnostic threshold used, awareness and acute clinical suspicion.6
No single diagnostic approach has gained acceptance as a reference standard for clinical practice. Clearly, in this scenario, the best strategy may firstly be avoiding all possible modifiable risks in the primary procedure.6
Diagnostic and therapeutic approaches of PJI
The predominant pathogens responsible for PJI are coagulase-negative staphylococci, staphylococcus aureus, streptococci, gram-negative bacilli, enterococci, and anaerobes.7 In about 10% of PJIs, mixed infections are detected, and in an additional 10%, no microorganisms are detected by methods currently used.8 This distribution has also been observed in Slovenian patients.9
Joint infection can present itself in many ways, ranging from fulminant joint sepsis with clear signs of infection to more indolent symptoms, such as pain or joint dysfunction. The mode of clinical presentation refers to the pathogenesis (planktonic bacteria vs. biofilms) and the microbial etiology of the infection (high vs. low virulence microorganisms). While fever and erythema are quite specific, their sensitivity for diagnosing of PJI is low.10 Pain and reduced range of motion are the most sensitive clinical signs in PJI, but the specificity is low as they overlap greatly with aseptic failures. Most likely there is also an unknown percentage of PJI that does not manifest clinically but can become clinically important with time or if some other conditions influencing local or systemic immune status develop (e.g., use of an immunosuppressive drug or similar).
As already stated, an accurate diagnosis is the starting point for effective treatment: underdiagnosis of PJI leads to inadequate treatment with serious consequences. Overdiagnosis results in inappropriate invasive treatment. Despite attempts to accurately define diagnostic criteria for PJI, diagnostic and therapeutic approaches in the management of PJI remain challenging. High-grade infection is easier to recognize, while low-grade infection and so called 'aseptic' loosening are problematic.6
Due to many reasons including the complexity of PJI presentation, geographical variations of
desired diagnostic accuracy, expensive testing availability, and disagreement about the accuracy of some of the included tests, a single definition for PJI has yet to be accepted. This would provide a unique practical guide for clinicians in the PJI management, and it would allow comparison between the studies.
To overcome this problem, the European Bone and Joint Infection Society (EBJIS) has recently proposed the novel 'traffic light' approach (Figure 1), which divides patients by the likelihood of infection (green or amber) or confirmed infection (red).11 The approach is not binary (i.e., 'infection' or 'no infection') and it has shown clinically to detect a higher percentage of lowgrade infections.8,12
Metal as risk factor for PJI and differential influence of bearing wear debris on local tissue immunocompetence
Several risk factors for PJI following arthroplasty surgery have been identified on the patient side, such as male gender, elevated BMI, higher ASA grade and specific comorbidities. Consequently, with targeted interventions applied pre-operatively patients can be medically optimized in order to reduce the risk of PJI. On the implant side metal bearings are among the most important and easily modifiable risk factors associated with PJI and have been associated with a higher risk of revision for PJI.
Observational studies have shown that the bearing material has an influence on the incidence of revision for PJI: ceramic-on-ceramic bearings having the lowest and metal-on-metal bearings having the highest whilst metal-on-polyethylene and ceramic-on-polyethylene have an intermediate incidence of revision for PJI.14,15 Epidemiological studies have found an association between PJI and the bearing material, but the causative mechanism has still to be determined. The pathogenic influence of metal-on-metal bearings has been widely investigated after THA patients developed adverse reactions to metal debris. In contrast ceramic-on-ceramic bearings are known for their high wear resistance and their excellent biocompatibility. Due to the very low concentration of ceramic wear particles produced in-vivo and their chemical-physical characteristics, an inappropriate inflammatory response in patients is very unlikely.
It may be speculated, that the incidence of clinically manifested PJI (especially low-grade PJI) may be influenced by the bearing surface type because of a differential influence of various bearing materials on local and systemic innate host defense response. In fact, when particulate debris of different bearing materials were added to human macrophages in tissue culture, it was found that macrophages reacted differently depending on the chemical composition and size of the particles. The ceramic composite particles were shown to induce no cytotoxic reaction in human macrophages, indicating the biological safety of the ceramic composite particles.4 On the other hand, metallic particles resulted cytotoxic for human macrophages. In addition, metallic particulate has also shown to increase excretion of some pro-inflammatory cytokines, suggesting a high inflammatory potential of metal wear particles. We may therefore assume that metallic bearing materials could locally immunocompromise periprosthetic tissue and promote the onset of PJI that would have remained silent in a less toxic environment.
It can be concluded that a possible explanation for the higher risk of PJI with metal bearings may be related to the generated metal particles and their biocorrosion products, which could locally immunocompromise periprosthetic tissue and promote the flare of infection. Research on this hypothesis is ongoing.
Prevention as best strategy against PJI
PJI is a real threat in THA, which can severely compromise patient health. Metal bearings have been identified as risk factor for PJI. Diagnosis and treatment are still very challenging representing a resource burden on the healthcare system, and any potential modifiable risk factor should be avoided a priori.
References
- Briggs AM, Cross MJ, Hoy DG, et al. Musculoskeletal health conditions represent a global threat to healthy aging: A report for the 2015 World Health Organization world report on ageing and health. Gerontologist. 2016;56 Suppl2:S243-S255. doi:10.1093/geront/gnw002.
- Kamaruzaman H, Kinghorn P, Oppong R. Cost-effectiveness of surgical interventions for the management of osteoarthritis: a systematic review of the literature. BMC Musculoskelet Disord. 2017;18(1):183. doi:10.1186/s12891-017-1540-2.
- Weber M, Renkawitz T, Voellner F, Craiovan B, Greimel F, Worlicek M, Grifka J, Benditz A. Revision surgery in total joint replacement is cost-intensive. Biomed Res Int. 2018:8987104. doi:10.1155/2018/8987104.
- Hodges NA, Sussman EM, Stegemann JP. Aseptic and septic prosthetic joint loosening: Impact of biomaterial wear on immune cell function, inflammation, and infection. Biomaterials. 2021;278:121127. doi:10.1016/j.biomaterials.2021.121127.
- de Steiger RN, Hatton A, Peng Y, Graves S. What is the risk of THA revision for ARMD in patients with non-metal-on-metal bearings? A study from the Australian National Joint Replacement Registry. Clin Orthop Relat Res.2020;478(6):1244-1253. doi:10.1097/CORR.0000000000001277.
- Villa JM, Pannu TS, Piuzzi N, Riesgo AM, Higuera CA. Evolution of diagnostic definitions for periprosthetic joint infection in total hip and knee arthroplasty. J Arthroplasty. 2020;35(3S):S9-S13. doi:10.1016/j.arth.2019.10.032.
- Papalini C, Pucci G, Cenci G, Mencacci A, Francisci D, Caraffa A, Antinolfi P, Pasticci MB. Prosthetic joint infection diagnosis applying the three-level European Bone and Joint Infection Society (EBJIS) approach. Eur J Clin Microbiol Infect Dis. 2022;41(5):771-778. doi:10.1007/s10096-022-04410-x.
- Tande AJ, Patel R. Prosthetic joint infection. Clin Microbiol Rev. 2014;27(2):302-345. doi:10.1128/CMR.00111-13.
- Rak M, Barlič-Maganja D, Kavčič M, Trebše R, Cőr A. Comparison of molecular and culture method in diagnosis of prosthetic joint infection. FEMS Microbiol Lett. 2013;343(1):42-48. doi:10.1111/1574-6968.12125.
- Shohat N, Goswami K, Tan TL, et al. Fever and erythema are specific findings in detecting infection following total knee arthroplasty. J Bone Jt Infect. 2019;4(2):92-98. doi:10.7150/jbji.30088.
- McNally M, Sousa R, Wouthuyzen-Bakker M, et al. Infographic: The EBJIS definition of periprosthetic joint infection. Bone Joint J. 2021;103-B(1):16-17. doi:10.1302/0301-620X.103B1.BJJ-2020-2417.
- Trebse R, Trampuz A. The definition of prosthetic joint infections (PJI). In: Trebse R, ed. Infected total joint arthroplasty. London: Springer; 2012:23-30.
- McNally M, Sousa R, Wouthuyzen-et al. Infographic: The EBJIS definition of periprosthetic joint infection. Bone Joint J. 2021;103-B(1):16-17. doi:10.1302/0301-620X.103B1.BJJ-2020-2417.
- Pitto RP, Sedel L. Periprosthetic joint infection in hip arthroplasty: is there an association between infection and bearing surface type? Clin Orthop Relat Res. 2016;474(10):2213-2218. doi:10.1007/s11999-016-4916-y.
- Holleyman RJ, Critchley RJ, Mason JM, Jameson SS, Reed MR, Malviya A. Ceramic bearings are associated with a significantly reduced revision rate in primary hip arthroplasty: An analysis from the National Joint Registry for England,Wales, Northern Ireland, and the Isle of Man. J Arthroplasty. 2021;36(10):3498-3506. doi:10.1016/j.arth.2021.05.027.